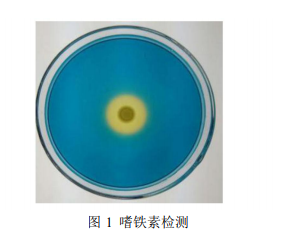
2022032903204373033

相关产品推荐更多 >
万千商家帮你免费找货
0 人在求购买到急需产品
- 详细信息
- 文献和实验
- 技术资料
- 库存:
50
- 英文名:
Modified CAS Agar Medium Kit
- 供应商:
上海博尔森生物科技有限公司
- 保存条件:
RT
- 规格:
1L
改良CAS固体培养基/嗜铁素检测固体培养基(套装)
包装内容:

产品说明:
CAS(Chrome azurol S)检测液是由铬天青(chrome azurol sulphonate, CAS)、溴化十六烷基三甲铵(hexadecy- ltrimethyl-ammonium bromide, HDTMA)和铁离子组成的一种复合物,呈亮蓝色。当蓝色检测平板中的铁离子被微生物分泌的嗜铁素夺走时,即可在微生物生长的菌落周围形成橘黄色晕圈,因此 CAS琼脂培养基平板可用于微生物产嗜铁素的检测。
通常 CAS 琼脂培养基平板配制方法较为复杂,对其配制方法进行改良,减少实验准备时间。该产品分为 CAS 培养基基础、已灭菌 10×缓冲剂和已灭菌 10×CAS 检测液 3 个部分。CAS 培养基中 Pipes 做缓冲剂,蛋白胨和葡糖糖提供氮源和碳源,钙盐和镁盐提供其他生长因子,琼脂是培养基的凝固剂。
产品组成:

配制方法:
1. 称取培养基基础 141 g,加去离子水定容至 800 mL,磁力搅拌溶解;
2. 115 ℃,20 min 灭菌;
3. 冷却至 50-60 ℃,向培养基基础中缓慢加入 60 ℃预热的 100 mL 10×缓冲液和 100 mL 10×CAS 检测液,混合均匀并不产生气泡,倾倒平皿;
4. 凝胶后用封口膜封口,4 ℃倒置备用。
使用说明(仅供参考):
1. 检测菌株:木霉属 Trichoderma spp.、芽胞杆菌 Bacillus spp.、气单孢菌 Aeromonas sp.、假单胞菌Pseudomonas sp.、绿脓杆菌 Pseudomonas aeruginosa、荧光假单胞菌 Pseudomonas fluorescensdeng 等;
2. 将待测菌株接种于平板,细菌培养 2-3 d,真菌培养 5-7 d,观查菌落周围有无橘黄色晕圈形成;
3. 结果参考,如图 1。
注意事项:
1. 注意无菌操作,避免微生物污染。
2. 根据菌株生长特性,可适当调整缓冲液的 pH 值。
3. 该培养基仅用于科研领域,不宜用于临床诊断或其它用途。
4. 称量时注意粉尘,佩戴口罩操作以避免引起呼吸道系统不适。
5. 干粉培养基使用后立即旋紧瓶盖,避免吸潮结块。贮存于避光、干燥处。未开封产品保质期三年。开封后根据存放条件的不同保质时间存在一定的差异。
常见问题:
a.待测菌株在 CAS 培养基上生长缓慢怎么办?
答: 可采用双层平板法,平板下层为每 900 mL 1.5%琼脂添加 100 mL 10×CAS 检测液的水琼脂,下层水琼脂凝固后,在倾倒基础培养基。
b.待测菌株不适合本基础培养基怎么办?
答:基础培养基可以根据待测菌株而定,但是基础培养基中不能含有铁离子,比如不含铁盐的 ISP 培养基。
特别提示:本公司的所有产品仅可用于科研实验,严禁用于临床医疗及其他非科研用途!
风险提示:丁香通仅作为第三方平台,为商家信息发布提供平台空间。用户咨询产品时请注意保护个人信息及财产安全,合理判断,谨慎选购商品,商家和用户对交易行为负责。对于医疗器械类产品,请先查证核实企业经营资质和医疗器械产品注册证情况。
 文献和实验
文献和实验培养基是液体、半固体或固体形式的,含天然或合成成分,用于保证微生物繁殖或保持其活力的物质。培养基的制备和使用是微生物实验室检测工作的重要环节,培养基自身质量的优劣、保存是否得当、配制使用是否正确等都直接影响到检测结果的准确性。本文对微生物实验室在培养基购置、贮存、制备、使用等方面应采取的质量控制措施进行讨论,谈一些观点和看法。希望有助于微生物检测工作的同行们更好的开展工作。 1 培养基的购置与验收 1.1 购置
”(swimming motility),而在固体培养基表面表现为“爬动”(swarming motility),有些细菌如变形杆菌就可以爬动侧鞭毛菌也有这种特性,这对于鉴定细菌很有帮助。 在检测某些细菌的鞭毛抗原时,如果该菌株有动力,用血琼脂平板培养的细菌鞭毛染色未见鞭毛或者发现鞭毛脱落,再使用血平板培养的菌落做血清凝集试验,出现阴性结果,这种情况下应该使用肉汤培养物做血清凝集试验,亦可用诱导方法恢复。 利用细菌鞭毛染色技术,可以将有动力的细菌进行归类
粪便标本应新鲜,病人的粪便标本最好在发病3-5病日内,使用抗生素之前。粪便采集量每份不少于5克,置于干净塑料袋或置于运送培养基中于6小时内送实验室检测,夏季标本的保存和运送要注意冷藏。原则上每天采集的标本可分两次送至实验室,即上午的标本中午12时前送到,下午的标本晚6时前送到,以便于及时开展检测医`学教育网搜集整理。 2.分离培养——以粪便标本为例 (1)冷增菌粪便与改良磷酸盐缓冲液以1:10混合于4℃增菌,并于10天,20天分别转种麦康凯MAC平板或耶尔森菌属专用选择性培养基CIN
 技术资料
技术资料暂无技术资料 索取技术资料










